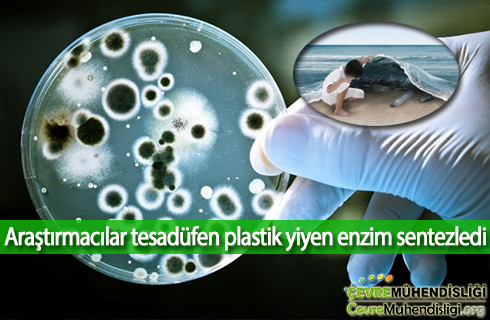
plastik yiyen bakteriler 2018haber

Bilim insanları çalışmaları sırasında plastik atıkların yok olmasını sağlayan bir enzim gerçekleştirdi. Enzimin hızla artan plastik sorununa karşı bir çare olabileceği düşünülüyor.
Bilim insanları çalışmaları sırasında plastik atıkların yok olmasını sağlayan bir enzim gerçekleştirdi. Enzimin hızla artan plastik sorununa karşı bir çare olabileceği düşünülüyor.
İsveç, atıkların yüzde 99'unu nasıl geri dönüştürüyor?
 "Türkiye'de muazzam potansiyel var"
"Türkiye'de muazzam potansiyel var"
1 bebekten 2 ton atık
 Denizli'de Pamukkale Üniversitesi (PAÜ) Mühendislik Fakültesi Tekstil Mühendisliği Bölümü öğretim üyesi Prof. Dr. Sema Palamutçu, bir bebeğin tuvalet eğitimini tamamlayana kadar ortalama 6 bin bebek bezi kullanıldığını, bunların oluşturduğu atık miktarının 2 tonu bulduğunu söyledi.
Denizli'de Pamukkale Üniversitesi (PAÜ) Mühendislik Fakültesi Tekstil Mühendisliği Bölümü öğretim üyesi Prof. Dr. Sema Palamutçu, bir bebeğin tuvalet eğitimini tamamlayana kadar ortalama 6 bin bebek bezi kullanıldığını, bunların oluşturduğu atık miktarının 2 tonu bulduğunu söyledi.
BM’den küresel ısınma uyarısı
 Birleşmiş Milletler (BM) Genel Sekreteri Antonio Guterres, “İklim değişikliği hala bizden çok daha hızlı ilerliyor. Bu olay insanlığın karşı karşıya olduğu en büyük tehdittir” dedi.
Birleşmiş Milletler (BM) Genel Sekreteri Antonio Guterres, “İklim değişikliği hala bizden çok daha hızlı ilerliyor. Bu olay insanlığın karşı karşıya olduğu en büyük tehdittir” dedi.
Gökova Körfezi, Marmaris, Ula ve Menteşe bölgesi imara açılıyor!
 Birinci sit alanında 34 bin 162 hektarlık alan, 12 bin 544 hektar olarak belirlendi.
Birinci sit alanında 34 bin 162 hektarlık alan, 12 bin 544 hektar olarak belirlendi.
Milli Eğitim 120 okulun çatısında güneş enerjisi sistemi kuracak
 Yatırımlar AB tarafından sağanacak 40 milyon avroluk kaynak ile gerçekleşecek
Yatırımlar AB tarafından sağanacak 40 milyon avroluk kaynak ile gerçekleşecek
Diğer Makaleler...
- Dünya Saat'ine Geri Sayım Başladı
- Bugünün kayak tesisleri, 20 yıl sonra yaz tatillerinin vazgeçilmezi olacak
- Göbeklitepe'ye beton döküldü
- Lego, artık bitki bazlı materyal kullanacak
- Karadeniz sahil yolu çöplüğe döndü
- Kuzey Kutbundaki Topraklar Antik Zamandan Kalma Karbon Yayıyor Olabilir
- Türkiye’de Arıtma Çamuru Yönetimi ve Eylem Planı Hazırlanması Projesi (TAÇYEP) Karadeniz Bölgesi Çalıştayı Samsun’da gerçekleştirildi.
- Proje Bedeli 82 Milyar TL Olan 431 Projeye ÇED Olumlu Kararı
- Ulusal Hava Kirleticileri Emisyon Envanteri Raporlaması
Sayfa 420 / 430













































